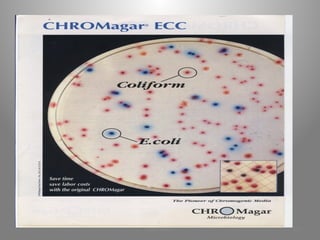
KOUA Amian 177
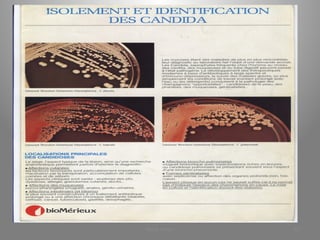
KOUA Amian 301

Le document présente le parcours académique et professionnel de Koua Amian, microbiologiste et hygiéniste des aliments, en détaillant ses formations, ses responsabilités et ses connaissances en microbiologie alimentaire. Il met en avant des informations sur le Staphylococcus aureus, notamment son pouvoir pathogène, ses caractéristiques morphologiques et biochimiques, ainsi que son rôle dans les toxi-infections alimentaires. Le document aborde également d'autres genres de bactéries, comme les streptocoques et le Leuconostoc, en précisant leur habitat, leurs propriétés et leur importance dans l'industrie agroalimentaire.